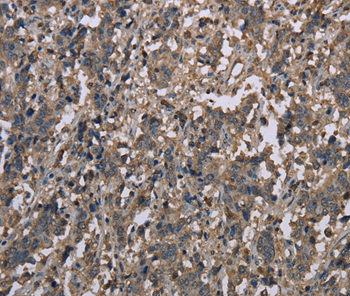

WB Suggested Anti-MCC Antibody Titration: 1.0 ug/ml Positive Control: MCF7 Whole Cell
MCC Rabbit Polyclonal Antibody
TA358328
Overview
- SupplierOriGene
- Product NameMCC Rabbit Polyclonal Antibody
- Delivery Days Customer14
- ApplicationsWestern Blot, ImmunoHistoChemistry
- CertificationResearch Use Only
- ClonalityPolyclonal
- HostRabbit
- Scientific DescriptionMCC Antibody - C-terminal region
- Storage Instruction-20°C,2°C to 8°C
- UNSPSC12352203